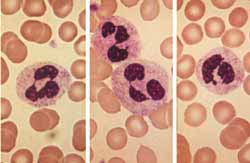
嗜酸性粒細胞白血病

流行病學
1912年由Stillman首先報導,發病率有明顯的種族差異白種人多見,黑種人次之,黃種人最少。
病因
少數病人可由特發性高嗜酸性粒細胞綜合徵轉化演變而來,也可以是極少數急性淋巴細胞白血病或慢性髓細胞白血病的晚期表現。
發病機制
發病機制未闡明,有報導患者造血細胞過度表達Wilms腫瘤基因,致細胞凋亡受抑。患者可有克隆性染色體異常,但無標誌染色體。
臨床表現
症狀
症狀本病病程的長短和快慢與嗜酸性粒細胞成熟程度有關,因此臨床上一般分為兩型。
1.急性型 本病與一般白血病不同的是感染出血較少主要是各個臟器的嗜酸性粒細胞浸潤,導致功能障礙,除了肝、脾、淋巴結的受累外還表現為心、肺中樞神經系統受累,臨床上常表現進行性心力衰竭可有奔馬律,心包摩擦音;咳嗽呼吸困難;如有中樞神經系統浸潤,表現為精神障礙、妄想、視力模糊、共濟失調、偏癱等。此外皮膚可出現紅斑、丘疹、小結等。
2.慢性型 發病緩慢,病程可延長至2~8年有乏力貧血、肝脾及淋巴結腫大。
併發症:
1.貧血嚴重時,可並發貧血性心臟病心衰。
2.合併感染髮熱,主要見於肺部感染。
3.並發神經系統症狀,精神障礙亦見物模糊及偏癱,癲癇。
診斷
 診斷
診斷國際上尚無統一的診斷標準,中國診斷標準如下。
1.臨床上有白血病的表現。
2.外周血 嗜酸性粒細胞明顯而持續增多,多數高達60%,並常有幼稚型嗜酸性粒細胞。
3.骨髓象 嗜酸性粒細胞增多,形態異常,核左移,有各階段幼稚型粒細胞可見粗大的嗜酸顆粒。原始細胞>5%
4.臟器有嗜酸性粒細胞浸潤
5.能除外寄生蟲病、過敏性疾病、結締組織病、高嗜酸性粒細胞綜合徵、慢性髓細胞白血病及其他原因所致嗜酸性粒細胞增多。
診斷評析:EL罕見,診斷必須十分慎重並充分除外其他原因引起的嗜酸性粒細胞增多症。血液學檢查,除嗜酸性粒細胞增多外其應有形態異常。血中出現幼稚嗜酸性粒細胞,骨髓中原始細胞>5%也是必備條件。遇條件不充分的可疑病例,應繼續尋找原發病,及仔細觀察病情變化。
鑑別診斷
 表1
表11.特發性高嗜酸性粒細胞綜合徵(idiopathic hypereosinophilic syndromeIHES) IHES也有血白細胞及嗜酸性粒細胞明顯增多,有嗜酸性粒細胞浸潤心臟肺及神經系統的徵象,病程中也可出現貧血和(或)血小板減少故易和EL混淆。二者鑑別點:①IMES的嗜酸性粒細胞形態正常,外周血無幼稚嗜酸性粒細胞,骨髓中原始細胞比例在正常範圍內均和EL不同;②IHES病程相對較長進展較慢,而EL病情進展快,貧血和血小板減少呈進行性但部分IHES臨床進展也較迅速,可短期致死,則主要靠血象及骨髓象鑑別之。
2.惡性疾病伴嗜酸性粒細胞增多症
 嗜酸性粒細胞白血病
嗜酸性粒細胞白血病(1)急性髓細胞白血病(AML)的M4E0型:即急性粒單核細胞白血病伴嗜酸性粒細胞增多,其有AML的臨床表現血和骨髓中嗜酸性粒細胞增多形態也可異常,故需和EL鑑別:①M4E0通常血和骨髓中嗜酸性粒細胞僅輕度增多<30%。占主要成分的仍是原始細胞及原始、幼稚單核細胞,此和EL顯然不同;②困難病例可行染色體及基因檢測,M4E0有標誌染色體異常即inv(16)(p13;q22),以及相應的融合基因MYH11/CBFβ。EL也有染色體異常,但均為非標誌性,如8、10號染色體三體、4q+45X、49XY等
(2)急性淋巴細胞白血病(ALL):少數ALL在病程中其血和骨髓中嗜酸性粒細胞增多,且中樞神經系統也常受累,故需和EL鑑別:①ALL通常急性起病而EL大多隱匿起病;②ALL患者常有淺表淋巴結腫大,而EL患者相對少見;③EL患者心臟受累常見,且累及全心(心內膜心肌、心包),而ALL心臟通常不受侵,僅見於蒽環類抗生素引起的心肌毒性,發生率也較低;④免疫分型,ALL表達淋巴細胞系列分化抗原,而EL則表達髓細胞系列分化抗原;⑤ALL發生嗜酸性粒細胞增多前,大多有典型的ALL臨床及實驗室特徵。
(3)骨髓增生性疾病(MPD):慢性髓細胞白血病(CML)、真性紅細胞增多症(PV)及特發性骨髓纖維化(IMF)等MPD在病程中,尤其是晚期可出現嗜酸性粒細胞增多,鑑別點為:①CML、PV及IMF在發生嗜酸性粒細胞增多前,各有很長的病程有相應的臨床表現及實驗室檢查特點。CML以中期幼稚的中性粒細胞增多為主,PV主要表現為紅細胞增多及相應的多血質的臨床表現,IMF以脾大及幼粒、幼紅細胞血症為特徵;②EL常見的心、肺及神經系統病變在MPD中常缺如;③CML還可藉助標記性Ph染色體及特異性融合基因BCR/ABL和EL區別。④IMF骨髓活檢顯示明顯的纖維化也不難和EL鑑別
(4)霍奇金淋巴瘤:其病程中常伴嗜酸性粒細胞增多,由於同時有發熱、淋巴結腫大,確診前必定行淋巴結活檢,因此從病理上較易和EL區別。
3.各種最常見的嗜酸性粒細胞增多症 臨床上寄生蟲感染變態反應、皮膚病、風濕性疾病是伴發嗜酸性粒細胞增多的最常見原因,也是與EL鑑別的重要內容。
(1)寄生蟲感染:寄生蟲的幼蟲在體內移行及侵入組織是誘發嗜酸性粒細胞增多的病理機制。糞便反覆尋找蟲卵及血清學檢測相應的抗體、特異性抗原皮膚試驗等是鑑別的主要手段。進行相應的驅蟲治療後,嗜酸性粒細胞降至正常也是診斷的依據。
(2)變態反應:支氣管哮喘、血管神經性水腫藥物過敏、血清病等均可致嗜酸性粒細胞增多。根據相應的病史、臨床表現,和EL鑑別應無困難。
(3)皮膚病:天皰瘡、皰疹樣皮炎等可引起白細胞及嗜酸性粒細胞增多,其他多種皮膚病也有類似併發症。由於臨床有明顯的皮損,而EL通常無皮膚受累,鑑別較為容易。
(4)風濕性疾病:結節性多動脈炎類風濕性關節炎等風濕性疾病及特殊的結締組織病(如嗜酸性筋膜炎)、嗜酸性肌痛綜合徵(由攝入被L-色氨酸污染的食品引起)均可致嗜酸性粒細胞升高。同樣由於原發病臨床表現均具特徵性,通常不易與EL混淆。
4.肺部疾病伴嗜酸性粒細胞增多 由於EL時肺部常受累,故必須和各種伴嗜酸性粒細胞增多的肺部疾病鑑別。
(1)Loeffer綜合徵:特徵為肺部影像學檢查顯示遊走性陰影及伴嗜酸性粒細胞增多部分患者系寄生蟲感染後幼蟲移行至肺所致。由於其肺部陰影呈遊走性且消失較快,屬一急性自限性病程,均不同於EL。
(2)肺嗜酸性粒細胞浸潤(pulmonary infiltration with eosinophils,PIE)綜合徵:表現為慢性、復發性呼吸道症狀,影像學檢查示肺部多形性浸潤,以及血嗜酸性粒細胞增多。大多數患者原因未明,僅少數和結核桿菌、布氏桿菌球孢子菌及病毒感染有關其病變局限於肺是鑑別的關鍵。
(3)熱帶嗜酸性粒細胞增多症:為絲蟲感染後的免疫反應狀態,主要表現為乾咳、喘憋、低熱兩肺哮鳴音,影像學檢查示肺間質斑點狀陰影,類似粟粒性肺結核。本病國內現已少見,主要發生在印度及東南亞國家。患者常有血清IgE升高,可檢出抗絲蟲抗體,枸櫞酸乙胺嗪(海群生)治療後迅速好轉,均為鑑別點。
5.嗜酸性淋巴肉芽腫 是一種少見病,表現為淺表淋巴結腫大伴血嗜酸性粒細胞增多,淋巴結病理為肉芽腫形成伴嗜酸性粒細胞浸潤本病對皮質激素反應良好,但部分病人停藥後可反覆。
6.其他伴嗜酸性粒細胞增多的疾病 罕見的遺傳性嗜酸性粒細胞增多症為常染色體顯性遺傳,有家族史,血嗜酸性粒細胞僅輕度升高,呈良性經過。偶見廣泛的乾酪樣淋巴結結核、放射治療後、脾切除術後、骨髓移植後並發的移植物抗宿主等,均可伴嗜酸性粒細胞增多。因為有明確的病史及相應的臨床表現,不難鑑別。
檢查
 檢查
檢查實驗室檢查
:1.血象 常見貧血和血小板減少,白細胞數明顯增高,可達(50~200)×109/L血片中嗜酸性粒細胞占20%~90%多數在60%以上,其中嗜酸性中幼粒及晚幼粒增多為主。原粒及早幼粒少見。
2.骨髓象 除原粒細胞比例增高外,嗜酸性粒細胞明顯增多並有左移根據細胞形態可分為三型:①原粒細胞型:血象和骨髓均有原粒細胞增多。②幼稚細胞型:除骨髓幼稚嗜酸性粒細胞明顯增多外,外周血中亦可見到此類細胞。③成熟細胞型:以成熟嗜酸性粒細胞增多為主,包括嗜酸性中、晚幼粒細胞增多,原粒細胞正常或稍增多。
3.染色體檢查 常有8號和10號染色體的三體型4q+ 及45X,49XY等染色體的異常。
其它輔助檢查:
1.細胞培養 外周血細胞CFU-GM生長結果近似慢性粒細胞白血病,其生長方式結合染色體檢查可用來區別嗜酸性粒細胞白血病與其他原因的嗜酸性粒細胞增多症
2.根據臨床表現、症狀、體徵、選擇胸片、CT、B超心電圖等檢查
相關檢查:嗜酸性粒細胞 染色體分析 白細胞計數 血小板
治療
EL原則上按AML治療,方案可沿用,部分病例對長春新鹼和羥基脲敏感,中樞神經系統累及者應鞘內注藥。並有組胺增多的臨床表現者,可試用H1和(或)H2受體阻滯藥
預後預防
預後:
本病預後不良,緩解率低本病自然病程多在2個月左右,很少持續至4個月,少數1周內死亡。死亡原因為大出血、心力衰竭伴支氣管肺炎、惡病質等。文獻報導1例患者用DA方案獲得完全緩解,生存63個多月。
預防:
積極治療原發病
